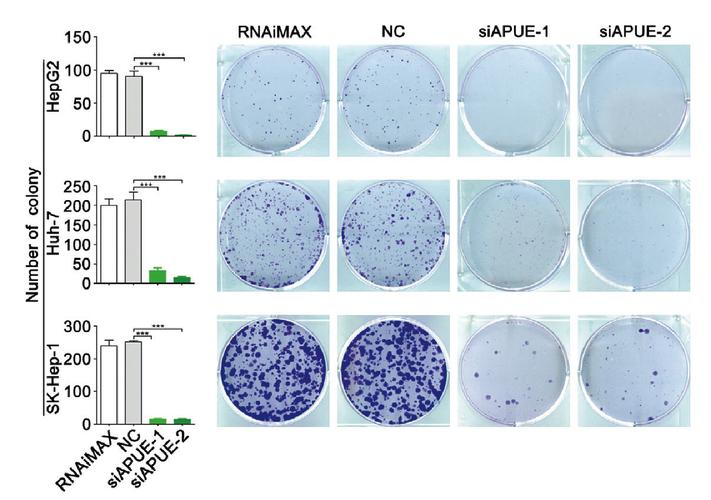

记者23日从中国科学院遗传与发育生物学研究所获悉,来自该所、中国科学院脑科学与智能技术卓越创新中心的科研人员,开发出一套高效组合技术策略,首次同时克服了体细胞克隆胚胎发育过程中面临的两大表观遗传障碍,创下了当前小鼠体细胞克隆效率的世界最高纪录,为哺乳动物高效体细胞克隆提供了一种切实可行的技术策略。相关研究成果发表于《先进科学》杂志。
在这项研究中,科研人员通过一套组合技术,成功解决了克隆胚胎发育的两大难题。首先,他们给胚胎使用了一种特殊药物,并注射了两种mRNA编码能去除基因调控表观遗传障碍的“修正酶”,有效克服了胚胎在着床前(植入子宫前)的发育障碍。同时,他们巧妙地利用“四倍体补偿技术”替换了克隆胚胎中未来会发育成胎盘的有缺陷细胞,从而解决了胚胎在着床后(植入子宫后)因胎盘问题导致的发育停滞。这套组合策略效果显著,移植胚胎最终发育成健康小鼠的比例达到约30%。
论文通讯作者、中国科学院遗传与发育生物学研究所研究员陆发隆表示,这项研究首次在单个克隆胚胎中,同时解决了着床前和着床后阻碍发育的两大关键表观遗传障碍,大幅提升了哺乳动物克隆的整体成功率,对未来高效克隆大型哺乳动物有很好的指导意义。





















